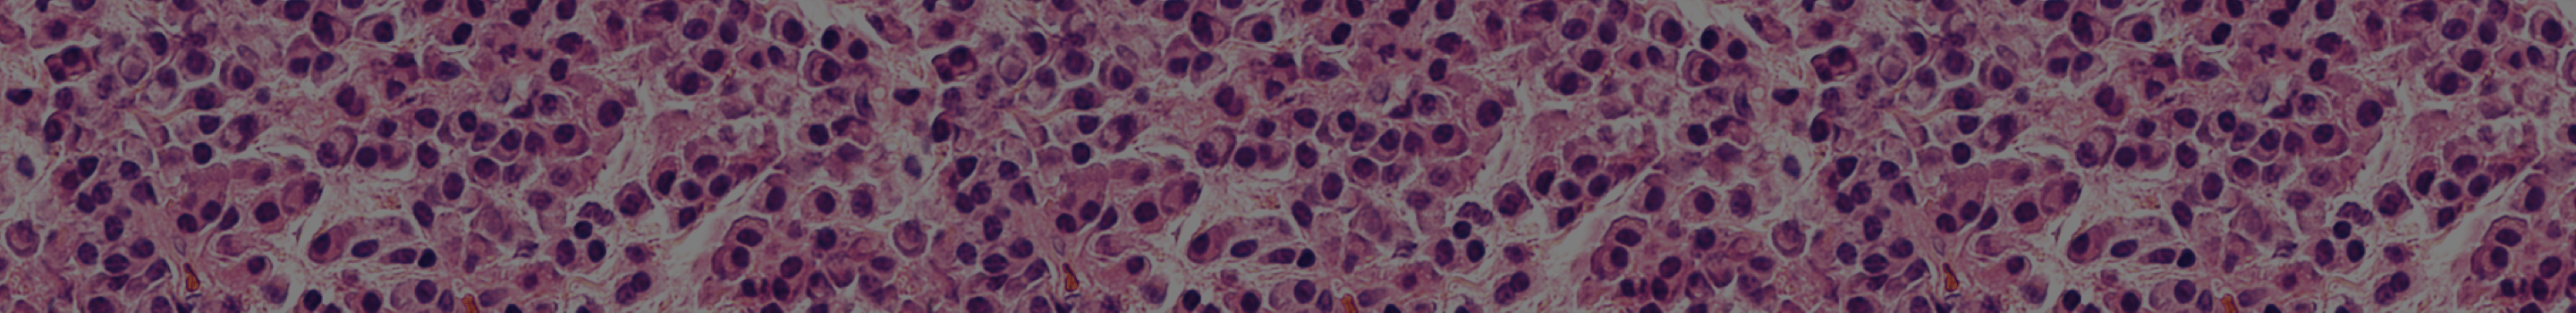

Multiple Myeloma (MM) is a complex disease primarily affecting older adults. This page will explore the evolution, underlying biology and epidemiology of MM.
In the majority of patients MM evolves from an asymptomatic pre-malignant precursor known as monoclonal gammopathy of undetermined significance (MGUS).
Adapted from Kyle et al. 2007, Rajkumar et al. 2014 and Mateos et al. 2018
MGUS, monoclonal gammopathy of undetermined significance; MM, Multiple Myeloma; SMM, smouldering Multiple Myeloma
Smouldering MM presents an asymptomatic clinical stage that is situated between MGUS and active MM. The estimated incidence of smouldering MM is between 0.4 and 0.9 cases per 100,000 people.
While approximately 1% of MGUS cases progress to MM per year, the rate of progression for smouldering MM is much higher – overall about 10% of patients per year progress within 5 years of diagnosis. The risk of progression from smouldering MM to active disease varies between patients, and they can be grouped as being at low-, intermediate- or high-risk of progression.
In symptomatic MM, malignant plasma cells undergo clonal expansion in the bone marrow. In almost all cases of MM (97%), these plasma cells secrete a monoclonal immunoglobulin – referred to as the M-protein. A very small percentage of patients, however, will have a non-secretory form of the disease.
The proliferating clonal plasma cells also produce an excess of either κ or λ light immunoglobulin chains, which circulate freely in the serum, unbound to heavy chains. This over-production of one free light chain (FLC) – known as the involved FLC – leads to an abnormal FLC ratio. Some patients with MGUS or smouldering MM show altered FLC ratio, which is related to risk of progression of MM.
The development of genetic abnormalities leads to the proliferation of abnormal plasma cells that may result in heterogeneous tumour cell clusters at multiple sites.
Learn about the pathological effects of MM, including elevated calcium, renal failure, anaemia and bone lesions (collectively known as 'CRAB' symptoms), and infections like pneumonia. The underlying genetic mechanisms that lead to tumour heterogeneity and ultimately disease progression will be discussed, highlighting why the heterogeneous nature of MM makes treatment very challenging.
MM represents 1% of all cancers diagnosed in Europe and approximately 10% of haematological malignancies.
Even though survival rates are increasing, MM remains an incurable disease. Global 5-year survival rates are now about 50–60% in patients aged 65–70 years or younger.
Worldwide, around 106,000 people die each year – 12 people every hour – from this disease. In 2018, 30,900 people died from MM in Europe alone.
The median age at diagnosis for MM is 69 years. The majority of people are first diagnosed when they are 65 years of age or older, while about one-third of newly diagnosed patients are at least 75 years of age. Men are at a slightly increased risk of developing MM compared with women.. MM is approximately twice as common among dark-skinned patients as white patients. dark-skinned patients have lower overall survival compared with white patients.
Early diagnosis is critical in MM. An array of diagnostic methods can be used to characterise a patient’s MM, allowing for individualised treatment and management.
The right treatment plan can improve a patient treatment response. Find out how treatment response is measured and what strides are being taken to optimise it.




